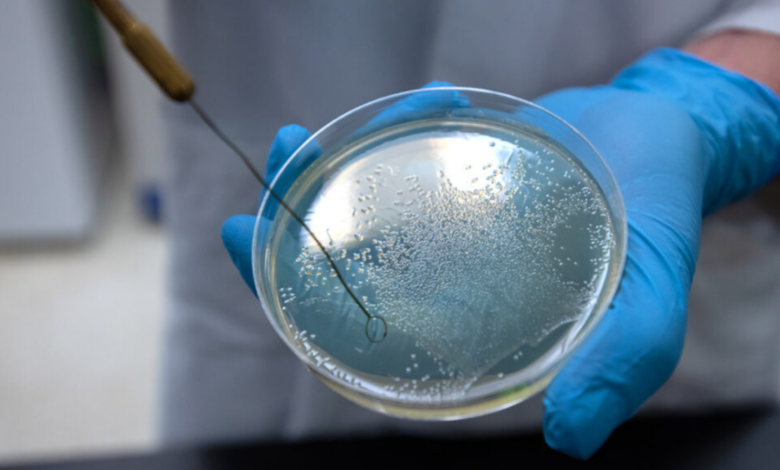
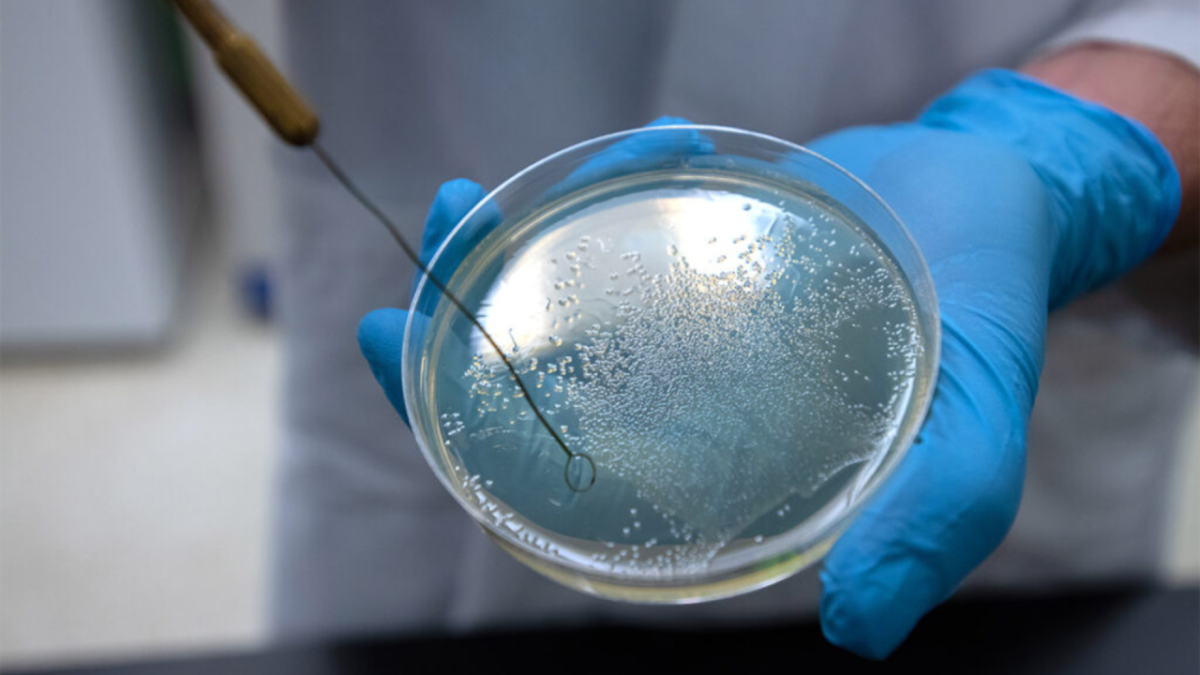

Study finds deadly bacteria with ‘thirst for human blood’

PORTLAND, Ore. (KOIN) – A research team led by Washington State University has discovered a phenomenon in which some of the world’s deadliest bacteria feed on human blood.
The researchers found that the bacteria are attracted to the liquid part of blood, which has nutrients they can use as food, in a phenomenon they called “bacterial vampirism.”
According to the researchers, this study could lead to innovations in medicine to help treat people with bloodstream infections.
During the study, researchers found the bacteria seemed especially drawn to serine, an amino acid found in human blood that is also a common ingredient in protein drinks.
“Bacteria infecting the bloodstream can be lethal,” said Arden Baylink, a professor at WSU’s College of Veterinary Medicine and corresponding author for the research. “We learned some of the bacteria that most commonly cause bloodstream infections actually sense a chemical in human blood and swim toward it.”
Researchers found at least three types of bacteria – Salmonella enterica, Escherichia coli and Citrobacter koseri – are attracted to human blood.
These bacteria are also a leading cause of death for people with inflammatory bowel diseases, and patients often experience intestinal bleeding that can act as entry points for the bacteria to enter the bloodstream, the university explained.
Using a high-powered microscope designed by Baylink, the team simulated intestinal bleeding by injecting microscopic amounts of serum and watching bacteria navigate to the source.
“The response is rapid — it takes less than a minute for the disease-causing bacteria to find the serum,” WSU said.
The researchers determined that salmonella has a special protein receptor called Tsr, which enables bacteria to sense and swim toward the blood. The researchers believe serine is one of the chemicals from blood that the bacteria can sense and consume.
“By learning how these bacteria are able to detect sources of blood, in the future we could develop new drugs that block this ability. These medicines could improve the lives and health of people with IBD who are at high risk for bloodstream infections,” Glenn said.
The study was published in the journal eLife and funded by WSU and the National Institute of Allergy and Infectious Diseases.
WSU mathematician Tom Asaki, and University of Oregon scientists Zealon Gentry-Lear, Michael Shavlik, and Michael Harms contributed to the research.




